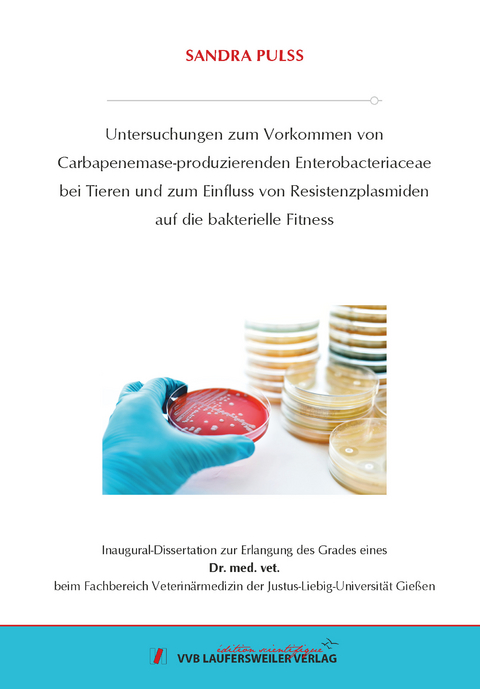
Untersuchungen zum Vorkommen von Carbapenemase-produzierenden Enterobacteriaceae bei Tieren und zum Einfluss von Resistenzplasmiden auf die bakterielle Fitness - Sandra Pulss

Untersuchungen zum Vorkommen von Carbapenemase-produzierenden Enterobacteriaceae bei Tieren und zum Einfluss von Resistenzplasmiden auf die bakterielle Fitness
Seiten
2021
VVB Laufersweiler Verlag
978-3-8359-6999-5 (ISBN)
VVB Laufersweiler Verlag
978-3-8359-6999-5 (ISBN)
- Keine Verlagsinformationen verfügbar
- Artikel merken
Carbapenemase-produzierende Enterobacteriaceae stellen ein großes Problem in der Therapie von bakteriellen Infektionen dar. Besonders nosokomiale Infektionen mit diesen Erregern treten sowohl in der Human- wie auch in der Tiermedizin immer häufiger auf. Um einen Überblick über das Auftreten multiresistenter Enterobacteriaceae zu erlangen, sind Screening-Studien unerlässlich.
Zur Abklärung der Ausbreitung von Carbapenemase-produzierenden Enterobacteriaceae in der Tiermedizin wurden von Juni 2012 bis Dezember 2016 insgesamt 19.025 E. coli, 1.607 Klebsiella spp. und 570 Enterobcter spp. plus 367 archivierte ESBL-/AmpC-produzierende Enterobacteriaceae aus früheren Untersuchungen von Schweinen (n = 10.899), Rindern (n = 1.889), kleinen Wiederkäuern (n = 246), Vögeln (n=132), Hunden (n=3.775), Katzen (n = 932), Pferden (n = 2.573), Nagetieren und Kaninchen (n = 428), Zoo- und Wildtiere (n = 644) und anderen (n = 51) auf eine Carbapenem-Resistenz untersucht. Das Probenmaterial stammte von Einsendungen ca. 1500 verschiedener veterinärmedizinischer Einrichtungen in unterschiedlichen Regionen in Deutschland (externe Kliniken), sowie aus den Kliniken für Pferde, Wiederkäuer, Schweine und Kleintiere und aus dem Institut für Veterinär-Pathologie der JLU Gießen (interne Kliniken).
Phänotypisch Carbapenem-non-sensible Isolate wurden mittels PCR auf die Carbapenemasegene blaNDM like, blaVIM like, blaKPC-like und blaOXA-48 like und im positiven Falle auf die ESBL- und AmpC-β Laktamasen blaCTX M like, blaSHV like, blaTEM like, blaOXA like, blaCMY like, blaDHA like, blaACC like und blaFOX like getestet.
Die OXA 48 like Carbapenemasen OXA-48 und OXA 181 konnten in 137 bzw. in zwei Fällen nachgewiesen werden.
Alle blaOXA-48-Gene wurden auf konjugativen, ca. 60 kb IncL-Plasmiden lokalisiert. Diese Plasmide wiesen eine Sequenzhomologie von bis zu 100 % zu in der Literatur beschriebenen IncL-Plasmiden aus der Humanmedizin auf. Die OXA-48-positiven Isolate stammen ausschließlich von Kleintieren und konnten nicht bei Nutztieren nachgewiesen werden.
In K. pneumoniae wurde diese Carbapenemase am häufigsten gefunden (n=86; 6,6 %), gefolgt von E. cloacae (n=28; 5 %), K. oxytoca (n=1; 0,3 %) und E. coli (n=22; 0,1 %). Bei den OXA-48-tragenden K. pneumoniae-Isolaten waren der ST11 und ST15, bei E. cloacae der ST506 und ST78 und bei E. coli der ST1196 besonders häufig vertreten. Nur 20 der 137 OXA-48-tragenden Isolate stammten von externen Tierarztpraxen. Die große Anzahl an OXA-48-positiven Isolaten aus der internen Kleintierklinik, die Ähnlichkeit der Plasmide hinsichtlich ihres Replikontyps und der Größe, das Sequenztypensprektrum und die Ergebnisse der Makrorestriktionsanalysen weisen auf eine hohe Klonalität von Isolaten innerhalb der verschiedenen Sequenztypen hin und indizieren eine nosokomiale Verbreitung entsprechender Isolate. Die Ähnlichkeit der OXA-48-Plasmide hinsichtlich ihres Replikontyps und der Größe sowie ihre in vitro gezeigten konjugativen Eigenschaften lassen zudem vermuten, dass eine Übertragung der Plasmide zwischen verschiedenen Spezies und/oder Sequenztypen stattgefunden hat. Die wiederholten Nachweise von Isolaten mit identischen Makrorestriktionsprofilen über lange Zeiträume von bis zu vier Jahren (K. pneumoniae ST15) könnten auf eine Persistenz in der Klinikumgebung hinweisen, wobei wiederhholte externe Einträge jedoch nicht ausgeschlossen werden können.
Die OXA-181-tragenden E. coli-Isolate stammen aus zwei unterschiedlichen Tieren aus einem italienischen Schweinebestand. Mittels MLST wurden der ST359 und ST641 ermittelt. Ein OXA-181-tragendes Isolat beherbergte zusätzlich die Colistin-Resistenzdeterminante MCR 1 und das Methyltransferasegen armA. Beide OXA-181-Plasmide besaßen außerdem das Quinolon-Resistenzgen qnrS1. Das Carbapenemase-Gen blaOXA 181 konnte auf einem ca. 50 kb großen, nicht-konjugativen IncX3-Plasmid nachgewiesen werden. Das Colistin-Resistenzgen mcr 1 wurde auf einem ca. 30 kb großen IncX4-Plasmid lokalisiert. Während in der Humanmedizin bereits OXA 181-tragende IncX3-Plasmide mit bis zu 100 % Sequenzhomologie zu den Funden dieser Studie beschrieben wurden, handelt es sich hier um den einzigen OXA 181-Nachweis in Schweinebeständen. Das nachgewiesene IncX4-Plasmid wies ebenfalls eine hohe Sequenzhomologie von bis zu 99,97 % zu bereits beschriebenen IncX4-Plasmiden auf. Die Kombination von OXA-181 und der Colistin-Resistenz MCR 1 in einem Bakterium wird hier das erste Mal beschrieben.
In den ergänzenden Untersuchungen zum Einfluss des OXA-48-Plasmids auf die Biofilmbildung konnte aufgrund differierender Biofilmexpression der Isolate sowohl mit Resistenzplasmid (Wildtypstamm) als auch ohne OXA-48-Plasmid (Plasmid-gecurte Variante) keine Aussage über einen einheitlichen Effekt des Resistenzplasmids auf die Fähigkeit zur Biofilmbildung gegeben werden. Dies deutet auf sehr komplexe Mechanismen der Biofilmbildung hin.
Auf die Sterblichkeit der Wachsmottenlarven konnte in den hier beschriebenen Untersuchungen kein statistisch signifikanter Einfluss des OXA-48-Plasmids ermittelt werden. Zusammenfassend betrachtet lag die Letalität der Wachsmottenlarven, die mit Isolaten mit oder ohne Resistenzplasmid infiziert wurden, im selben Bereich.
Diese Arbeit konnte einen Überblick über die Verbreitung Carbapenemase-produzierender Enterobacteriaceae bei Tieren in Deutschland schaffen und Aufschluss über die nosokomiale Ausbreitung von verschiedenen Spezies und Sequenztypen mit einem OXA-48-Plasmid gleicher Größe und identischen Replikontyps in einer Tierklinik geben. Für die gezielte Bekämpfung von Tierklinik-assoziierten Infektionsgeschehen sind, analog zur Humanmedizin, Surveillance-Studien von großer Bedeutung. Die Kenntnis zur molekularen Epidemiologie von Carbapenemase-produzierenden Bakterien und deren Resistenzplasmiden ist eine wesentliche Voraussetzung für die Implementierung bzw. Optimierung von präventiven Hygienemaßnahmen in Tierkliniken. Es konnte gezeigt werden, dass Carbapenemase-Bildner aus der Veterinär- und Humanmedizin wesentliche gemeinsame Eigenschaften aufweisen. Dies verdeutlicht einmal mehr, dass der globalen Antibiotikaresistenz-Problematik nur mit einem „One Health“-Ansatz begegnet werden kann. Carbapenemase-producing Enterobacteriaceae pose a serious threat for treatment of bacterial infections. Particularly nosocomial infections with these pathogens have occured more frequently over the last decades. To gain an overview of incidence of multiresistant Enterobacteriaceae, screening studies are essential.
Between June 2012 and December 2016, 19,025 E. coli, 1,607 Klebsiella spp. and 570 Enterobacter spp. were examined for carbapenem-non-susceptibility. Additionally, 367 archived ESBL /AmpC β Lactamase-producing Enterobacteriaceae were tested. Samples originated from swine (n = 10,899), cattle (n = 1,889), small ruminants (n = 246), birds (n=132), dogs (n=3,775), cats (n = 932), horses (n = 2,573), pet animals and rodents (n = 428), zoo and wildlife animals (n = 644) and others (n = 51). The sample material originated from about 1,500 different veterinary clinics from different regions throughout Germany (external clinics), as well as from the clinics for horses, ruminants, pigs and small animals and from the Institute of Veterinary Pathology of the JLU Giessen (internal clinics). Phenotypical Carbapenem-non-susceptible isolates were tested by PCR for blaNDM like, blaVIM like, blaKPC-like and blaOXA-48 like and in a positive case also for ESBL and AmpC β laktamases blaCTX M like, blaSHV like, blaTEM like, blaOXA like, blaCMY like, blaDHA like, blaACC like and blaFOX like.
OXA 48 like carbapenemases OXA 48 and OXA 181 were detected in 137 and 2 isolates, respectively.
BlaOXA-48 was located on an approximately 60¬ kb IncL-plasmid in all cases. These plasmids exhibited a high similarity of up to 100 % to published sequences of human OXA 48 plasmids. OXA-48-plasmids were only discovered in isolates of small animal origin but not in livestock.
K. pneumoniae was the most prevalent OXA-48-producer (n=86; 6.6 %), followed by E. cloacae (n=28; 5 %), K. oxytoca (n=1; 0.3 %) and E. coli (n=22; 0.1 %).
Predominant STs for OXA 48-positive isolates proved to be ST11 and ST15 for K. pneumoniae, ST506 and ST78 for E. cloacae and ST1196 for E. coli.
The minority (n = 20) of OXA 48 isolates originated from external veterinary practices. High detection rates in the sample material from internal clinics, similarity of plasmids size and replicontype, STs and results of macrorestriction analysis suggest high clonality and nosocomial events of according isolates. Size and replicontype of OXA-48-plasmids and in vitro conjugation experiments hypothesize plasmid-transfer between different spezies and STs. Repeated detection of isolates with identical macrorestriction profiles over long periods of up to four years (K. pneumoniae, ST15) might indicate persistence in clinic ambience, however, repeated external entries cannot be ruled out.
OXA 181 carrying E. coli were obtained from two different pigs from an Italian livestock farm. MLST revealed ST359 and ST641. One of the OXA 181-positive isolates was also positive for colistin resistance MCR 1 and methyltransferase gene armA. Moreover, both OXA-181-plasmids harboured quinolone-resistance gene qnrS1. BlaOXA 181 was located on an approximately 50 kb non-conjugative IncX3-plasmid, mcr 1 on an approximately 30 kb IncX4-plasmid. The two OXA 181 plasmids revealed up to 100 % sequence identity to human OXA 181 IncX3-plasmids, but this is the first report about OXA 181 in pig livestock. The detected IncX4-plasmid revealed sequence-homology of 99,97 % to already published IncX-4-plasmids. This is also the first report about the combination of carbapenemase gene blaOXA 181 and colistin-resistance gene mcr 1 in a sole bacterium.
In supplementary studies concerning the influence of the OXA-48 plasmid on biofilm formation, no statement could be made about a uniform effect of the resistance plasmid on the ability to form biofilms. This suggests very complex mechanisms of biofilm formation.
No statistically significant effect of the OXA-48 plasmid on the mortality of wax moth larvae could be determined in this study. In summary, the lethality of wax moth larvae infected with isolates with or without resistance plasmid was in the same range.
This study provided an overview regarding the spread of carbapenemase-producing Enterobacteriaceae in animals in Germany and supplied information on the nosocomial spread of different species and sequence types exhibiting an OXA-48 plasmid of equal size and identical replicon type in a veterinary clinic. Surveillance studies are of great importance for the targeted control of veterinary hospital-associated infectious events, analog to human medicine. Knowledge of the molecular epidemiology of carbapenemase-producing bacteria and their resistance plasmids is an essential prerequisite for the implementation or optimization of preventive hygiene measures in veterinary clinics. It was shown that carbapenemase producers from veterinary and human medicine have essential properties in common. This illustrates again that the global antibiotic resistance problem can only be fought with a "one health" approach.
Zur Abklärung der Ausbreitung von Carbapenemase-produzierenden Enterobacteriaceae in der Tiermedizin wurden von Juni 2012 bis Dezember 2016 insgesamt 19.025 E. coli, 1.607 Klebsiella spp. und 570 Enterobcter spp. plus 367 archivierte ESBL-/AmpC-produzierende Enterobacteriaceae aus früheren Untersuchungen von Schweinen (n = 10.899), Rindern (n = 1.889), kleinen Wiederkäuern (n = 246), Vögeln (n=132), Hunden (n=3.775), Katzen (n = 932), Pferden (n = 2.573), Nagetieren und Kaninchen (n = 428), Zoo- und Wildtiere (n = 644) und anderen (n = 51) auf eine Carbapenem-Resistenz untersucht. Das Probenmaterial stammte von Einsendungen ca. 1500 verschiedener veterinärmedizinischer Einrichtungen in unterschiedlichen Regionen in Deutschland (externe Kliniken), sowie aus den Kliniken für Pferde, Wiederkäuer, Schweine und Kleintiere und aus dem Institut für Veterinär-Pathologie der JLU Gießen (interne Kliniken).
Phänotypisch Carbapenem-non-sensible Isolate wurden mittels PCR auf die Carbapenemasegene blaNDM like, blaVIM like, blaKPC-like und blaOXA-48 like und im positiven Falle auf die ESBL- und AmpC-β Laktamasen blaCTX M like, blaSHV like, blaTEM like, blaOXA like, blaCMY like, blaDHA like, blaACC like und blaFOX like getestet.
Die OXA 48 like Carbapenemasen OXA-48 und OXA 181 konnten in 137 bzw. in zwei Fällen nachgewiesen werden.
Alle blaOXA-48-Gene wurden auf konjugativen, ca. 60 kb IncL-Plasmiden lokalisiert. Diese Plasmide wiesen eine Sequenzhomologie von bis zu 100 % zu in der Literatur beschriebenen IncL-Plasmiden aus der Humanmedizin auf. Die OXA-48-positiven Isolate stammen ausschließlich von Kleintieren und konnten nicht bei Nutztieren nachgewiesen werden.
In K. pneumoniae wurde diese Carbapenemase am häufigsten gefunden (n=86; 6,6 %), gefolgt von E. cloacae (n=28; 5 %), K. oxytoca (n=1; 0,3 %) und E. coli (n=22; 0,1 %). Bei den OXA-48-tragenden K. pneumoniae-Isolaten waren der ST11 und ST15, bei E. cloacae der ST506 und ST78 und bei E. coli der ST1196 besonders häufig vertreten. Nur 20 der 137 OXA-48-tragenden Isolate stammten von externen Tierarztpraxen. Die große Anzahl an OXA-48-positiven Isolaten aus der internen Kleintierklinik, die Ähnlichkeit der Plasmide hinsichtlich ihres Replikontyps und der Größe, das Sequenztypensprektrum und die Ergebnisse der Makrorestriktionsanalysen weisen auf eine hohe Klonalität von Isolaten innerhalb der verschiedenen Sequenztypen hin und indizieren eine nosokomiale Verbreitung entsprechender Isolate. Die Ähnlichkeit der OXA-48-Plasmide hinsichtlich ihres Replikontyps und der Größe sowie ihre in vitro gezeigten konjugativen Eigenschaften lassen zudem vermuten, dass eine Übertragung der Plasmide zwischen verschiedenen Spezies und/oder Sequenztypen stattgefunden hat. Die wiederholten Nachweise von Isolaten mit identischen Makrorestriktionsprofilen über lange Zeiträume von bis zu vier Jahren (K. pneumoniae ST15) könnten auf eine Persistenz in der Klinikumgebung hinweisen, wobei wiederhholte externe Einträge jedoch nicht ausgeschlossen werden können.
Die OXA-181-tragenden E. coli-Isolate stammen aus zwei unterschiedlichen Tieren aus einem italienischen Schweinebestand. Mittels MLST wurden der ST359 und ST641 ermittelt. Ein OXA-181-tragendes Isolat beherbergte zusätzlich die Colistin-Resistenzdeterminante MCR 1 und das Methyltransferasegen armA. Beide OXA-181-Plasmide besaßen außerdem das Quinolon-Resistenzgen qnrS1. Das Carbapenemase-Gen blaOXA 181 konnte auf einem ca. 50 kb großen, nicht-konjugativen IncX3-Plasmid nachgewiesen werden. Das Colistin-Resistenzgen mcr 1 wurde auf einem ca. 30 kb großen IncX4-Plasmid lokalisiert. Während in der Humanmedizin bereits OXA 181-tragende IncX3-Plasmide mit bis zu 100 % Sequenzhomologie zu den Funden dieser Studie beschrieben wurden, handelt es sich hier um den einzigen OXA 181-Nachweis in Schweinebeständen. Das nachgewiesene IncX4-Plasmid wies ebenfalls eine hohe Sequenzhomologie von bis zu 99,97 % zu bereits beschriebenen IncX4-Plasmiden auf. Die Kombination von OXA-181 und der Colistin-Resistenz MCR 1 in einem Bakterium wird hier das erste Mal beschrieben.
In den ergänzenden Untersuchungen zum Einfluss des OXA-48-Plasmids auf die Biofilmbildung konnte aufgrund differierender Biofilmexpression der Isolate sowohl mit Resistenzplasmid (Wildtypstamm) als auch ohne OXA-48-Plasmid (Plasmid-gecurte Variante) keine Aussage über einen einheitlichen Effekt des Resistenzplasmids auf die Fähigkeit zur Biofilmbildung gegeben werden. Dies deutet auf sehr komplexe Mechanismen der Biofilmbildung hin.
Auf die Sterblichkeit der Wachsmottenlarven konnte in den hier beschriebenen Untersuchungen kein statistisch signifikanter Einfluss des OXA-48-Plasmids ermittelt werden. Zusammenfassend betrachtet lag die Letalität der Wachsmottenlarven, die mit Isolaten mit oder ohne Resistenzplasmid infiziert wurden, im selben Bereich.
Diese Arbeit konnte einen Überblick über die Verbreitung Carbapenemase-produzierender Enterobacteriaceae bei Tieren in Deutschland schaffen und Aufschluss über die nosokomiale Ausbreitung von verschiedenen Spezies und Sequenztypen mit einem OXA-48-Plasmid gleicher Größe und identischen Replikontyps in einer Tierklinik geben. Für die gezielte Bekämpfung von Tierklinik-assoziierten Infektionsgeschehen sind, analog zur Humanmedizin, Surveillance-Studien von großer Bedeutung. Die Kenntnis zur molekularen Epidemiologie von Carbapenemase-produzierenden Bakterien und deren Resistenzplasmiden ist eine wesentliche Voraussetzung für die Implementierung bzw. Optimierung von präventiven Hygienemaßnahmen in Tierkliniken. Es konnte gezeigt werden, dass Carbapenemase-Bildner aus der Veterinär- und Humanmedizin wesentliche gemeinsame Eigenschaften aufweisen. Dies verdeutlicht einmal mehr, dass der globalen Antibiotikaresistenz-Problematik nur mit einem „One Health“-Ansatz begegnet werden kann. Carbapenemase-producing Enterobacteriaceae pose a serious threat for treatment of bacterial infections. Particularly nosocomial infections with these pathogens have occured more frequently over the last decades. To gain an overview of incidence of multiresistant Enterobacteriaceae, screening studies are essential.
Between June 2012 and December 2016, 19,025 E. coli, 1,607 Klebsiella spp. and 570 Enterobacter spp. were examined for carbapenem-non-susceptibility. Additionally, 367 archived ESBL /AmpC β Lactamase-producing Enterobacteriaceae were tested. Samples originated from swine (n = 10,899), cattle (n = 1,889), small ruminants (n = 246), birds (n=132), dogs (n=3,775), cats (n = 932), horses (n = 2,573), pet animals and rodents (n = 428), zoo and wildlife animals (n = 644) and others (n = 51). The sample material originated from about 1,500 different veterinary clinics from different regions throughout Germany (external clinics), as well as from the clinics for horses, ruminants, pigs and small animals and from the Institute of Veterinary Pathology of the JLU Giessen (internal clinics). Phenotypical Carbapenem-non-susceptible isolates were tested by PCR for blaNDM like, blaVIM like, blaKPC-like and blaOXA-48 like and in a positive case also for ESBL and AmpC β laktamases blaCTX M like, blaSHV like, blaTEM like, blaOXA like, blaCMY like, blaDHA like, blaACC like and blaFOX like.
OXA 48 like carbapenemases OXA 48 and OXA 181 were detected in 137 and 2 isolates, respectively.
BlaOXA-48 was located on an approximately 60¬ kb IncL-plasmid in all cases. These plasmids exhibited a high similarity of up to 100 % to published sequences of human OXA 48 plasmids. OXA-48-plasmids were only discovered in isolates of small animal origin but not in livestock.
K. pneumoniae was the most prevalent OXA-48-producer (n=86; 6.6 %), followed by E. cloacae (n=28; 5 %), K. oxytoca (n=1; 0.3 %) and E. coli (n=22; 0.1 %).
Predominant STs for OXA 48-positive isolates proved to be ST11 and ST15 for K. pneumoniae, ST506 and ST78 for E. cloacae and ST1196 for E. coli.
The minority (n = 20) of OXA 48 isolates originated from external veterinary practices. High detection rates in the sample material from internal clinics, similarity of plasmids size and replicontype, STs and results of macrorestriction analysis suggest high clonality and nosocomial events of according isolates. Size and replicontype of OXA-48-plasmids and in vitro conjugation experiments hypothesize plasmid-transfer between different spezies and STs. Repeated detection of isolates with identical macrorestriction profiles over long periods of up to four years (K. pneumoniae, ST15) might indicate persistence in clinic ambience, however, repeated external entries cannot be ruled out.
OXA 181 carrying E. coli were obtained from two different pigs from an Italian livestock farm. MLST revealed ST359 and ST641. One of the OXA 181-positive isolates was also positive for colistin resistance MCR 1 and methyltransferase gene armA. Moreover, both OXA-181-plasmids harboured quinolone-resistance gene qnrS1. BlaOXA 181 was located on an approximately 50 kb non-conjugative IncX3-plasmid, mcr 1 on an approximately 30 kb IncX4-plasmid. The two OXA 181 plasmids revealed up to 100 % sequence identity to human OXA 181 IncX3-plasmids, but this is the first report about OXA 181 in pig livestock. The detected IncX4-plasmid revealed sequence-homology of 99,97 % to already published IncX-4-plasmids. This is also the first report about the combination of carbapenemase gene blaOXA 181 and colistin-resistance gene mcr 1 in a sole bacterium.
In supplementary studies concerning the influence of the OXA-48 plasmid on biofilm formation, no statement could be made about a uniform effect of the resistance plasmid on the ability to form biofilms. This suggests very complex mechanisms of biofilm formation.
No statistically significant effect of the OXA-48 plasmid on the mortality of wax moth larvae could be determined in this study. In summary, the lethality of wax moth larvae infected with isolates with or without resistance plasmid was in the same range.
This study provided an overview regarding the spread of carbapenemase-producing Enterobacteriaceae in animals in Germany and supplied information on the nosocomial spread of different species and sequence types exhibiting an OXA-48 plasmid of equal size and identical replicon type in a veterinary clinic. Surveillance studies are of great importance for the targeted control of veterinary hospital-associated infectious events, analog to human medicine. Knowledge of the molecular epidemiology of carbapenemase-producing bacteria and their resistance plasmids is an essential prerequisite for the implementation or optimization of preventive hygiene measures in veterinary clinics. It was shown that carbapenemase producers from veterinary and human medicine have essential properties in common. This illustrates again that the global antibiotic resistance problem can only be fought with a "one health" approach.
| Erscheinungsdatum | 10.01.2022 |
|---|---|
| Reihe/Serie | Edition Scientifique |
| Verlagsort | Gießen |
| Sprache | deutsch |
| Maße | 148 x 210 mm |
| Gewicht | 200 g |
| Themenwelt | Veterinärmedizin ► Allgemein |
| Schlagworte | Bakterien • Plasmide • Resistenz |
| ISBN-10 | 3-8359-6999-4 / 3835969994 |
| ISBN-13 | 978-3-8359-6999-5 / 9783835969995 |
| Zustand | Neuware |
| Informationen gemäß Produktsicherheitsverordnung (GPSR) | |
| Haben Sie eine Frage zum Produkt? |
Mehr entdecken
aus dem Bereich
aus dem Bereich
Buch | Softcover (2025)
Mensch & Buch (Verlag)
CHF 69,85